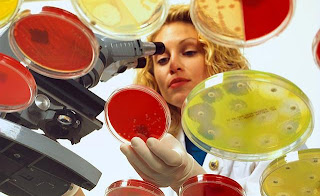

Bi se radi (ponovno) seznanili z osnovami določene vede oz. teme? Ste na primer pozabili princip mitoze in mejoze? The Khan Academy ponuja brezplačne kratke in lahko razumljive video predstavitve tem s področja matematike, zgodovine, financ, kemije, biologije, astronomije, ekonomije in računalništva.
nedelja, 31. julij 2011
sreda, 27. julij 2011
Poklic mikrobiologa
Ugani kdo: potrpežljiv, ustvarjalen, pozoren na podrobnosti, obožuje reševanje ugank ...
To je seveda mikrobiolog! Več o tem, kakšen je poklic mikrobiologa, tukaj.
To je seveda mikrobiolog! Več o tem, kakšen je poklic mikrobiologa, tukaj.
![]() |
| Mikrobiolog je znanstvenik, ki preučuje mikrobe (bakterije, arheje, glive, protiste) in njihov vpliv na svet okoli njih. |
petek, 8. julij 2011
O ošpicah in pomembnosti cepljenja
Sedaj, ko so se po desetih letih odsotnosti v Sloveniji ponovno pojavile ošpice (angl. measles, rubiola), smo se vsi (upam) vprašali, ali smo cepljeni proti tej bolezni oz. ali smo jo preboleli – v obeh primerih smo namreč proti bolezni doživljenjsko zaščiteni. Vendar – kaj točno sploh so ošpice? Sem kot otrok prebolel ošpice, norice, rdečke, šesto bolezen ali kaj drugega?
![]() |
| Običajni bolezenski znaki so nahod, kašelj, povišana telesna temperatura, vnetje očesne veznice in rdečkasti izpuščaji. |
Ošpice povzroča virus ošpic iz družine paramiksovirusov. Gre za virus z enovijačnim RNA genomom in vijačno simetrijo. V tarčno celico vstopa z zlitjem, izstopa pa z brstenjem. Virus se namnoži v bezgavkah, nato pa iz mononuklearnih celic vstopi v kri. S krvjo se nato razširi do tarčnih organov, ki so koža, ledvice, pljuča, žleze slinavke, nosna in ustna sluznica, ušesa, črevesje ter celo možgani, kjer lahko virus povzroči redko kronično vnetje možganske ovojnice, imenovano subakutni sklerozni encefalitis (SSPE). Za virus ošpic je torej značilna generalizirana okužba.
![]() |
| Tarčni organi in zapleti, ki jih virus ošpic povzroča. *Krup je obloga v grlu, ki lahko bolnika zaduši |
Povprečna inkubacijska doba je 14 dni, možna pa je tudi zelo dolga inkubacijska doba (t. i. počasni virus), ki je redka in se kaže v okužbi centralnega živčevja – taka okužba je smrtna. Za ošpice so značilni makulopapulozni izpuščaji (eksantem) na koži, spremljajo pa jih tudi izpuščaji na ustni sluznici (enantem), imenovani Koplikove pege, ki se pojavijo dan ali dva pred kožnimi izpuščaji. Makulopapularne izpuščaje povzročajo citotoksični limfociti T, ki uničujejo okužene celice. Pojav izpuščajev je tako znak učinkovitega imunskega odziva in okrevanja; pri osebah z oslabljenim imunskim sistemom se izpuščaji ne pojavijo. Ošpice so izredno nalezljiva bolezen. Značilen je dvofazni potek bolezni: prodromalni fazi s splošnimi znaki in značilnimi Koplikovimi pegami po ustni sluznici, čez 14 dni pa sledi obdobje generaliziranega makulopapuloznega izpuščaja z visoko vročino, ki traja sedem dni. V prodromalni in akutni fazi je virus prisoten v vseh telesnih tekočinah (tudi respiratornih izločkih) in se prenaša kapljično, v gostitelja pa vstopa preko očesne ali ustne sluznice. Okužimo se torej lahko z vdihovanjem virusnih delcev ali pa neposrednim vnosom virusa v telo, npr. z roko v usta (podrobnejši opis načinov prenosa tukaj).
Cepivo MMR, tj. cepivo proti ošpicam, mumpsu in rdečkam, se je pojavilo v šestdesetih letih 20. stoletja. Od leta 1990 v Sloveniji poteka množično »obvezno« cepljenje osnovnošolcev z MMR, ki je edini (!) razlog za drastično zmanjšanje obolelih povsod po svetu in desetletno odsotnost virusa v Sloveniji. Otroke prvič cepijo pri 12 mesecih starosti in ponovno pri petih letih starosti. Splošne značilnosti omenjenih bolezni in cepiva lahko preberete tukaj. S precepljenjem celotne populacije bi dosegli popoln izbris (izkoreninjenje) virusa ošpic, kakor so to dosegli leta 1997 z virusom črnih koz in se trudijo doseči s poliovirusom. Na kakšen način jim (nam) je to uspelo? S CEPLJENJEM!
Morda ste slišali za polemiko, povezano s cepivom MMR, ki naj bi povzročalo avtizem. Naj povem, da je bila vsakršna povezanost cepiva z avtizmom ovržena, saj je Andrew Wakefield, avtor raziskave, objavljene v letu 1998, med drugim prikazal lažne rezultate, s katerimi je želel dokazati tudi povezanost z avtističnim enterokolitisom (motnjo, ki si jo je izmislil kar sam). Posledica njegove lažne raziskave pa je bil znaten upad precepljenosti prebivalstva z MMR in izbruhi ošpic ter mumpsa (1, 2, 3). Na Irskem so ošpice zaradi neprecepljenosti v letu 2000 zahtevale tri smrtne žrtve (4).
Jaz sem preveril in sem bil cepljen z MMR. Pa vi?
Naročite se na:
Komentarji (Atom)